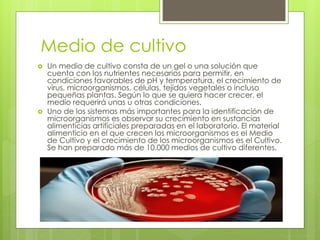
Medio de cultivo
 Un medio de cultivo consta de un gel o una solución que
cuenta con los nutrientes necesarios para permitir, en
condiciones favorables de pH y temperatura, el crecimiento de
virus, microorganismos, células, tejidos vegetales o incluso
pequeñas plantas. Según lo que se quiera hacer crecer, el
medio requerirá unas u otras condiciones.
 Uno de los sistemas más importantes para la identificación de
microorganismos es observar su crecimiento en sustancias
alimenticias artificiales preparadas en el laboratorio. El material
alimenticio en el que crecen los microorganismos es el Medio
de Cultivo y el crecimiento de los microorganismos es el Cultivo.
Se han preparado más de 10.000 medios de cultivo diferentes.

Este documento describe diferentes tipos de secreciones y cómo cultivarlas en el laboratorio. Explica que las secreciones son sustancias expulsadas por las glándulas y que los cultivos permiten identificar microorganismos. Luego detalla procedimientos para obtener muestras de esputo, secreciones nasofaríngeas, traqueales, heridas y sangre para su análisis.